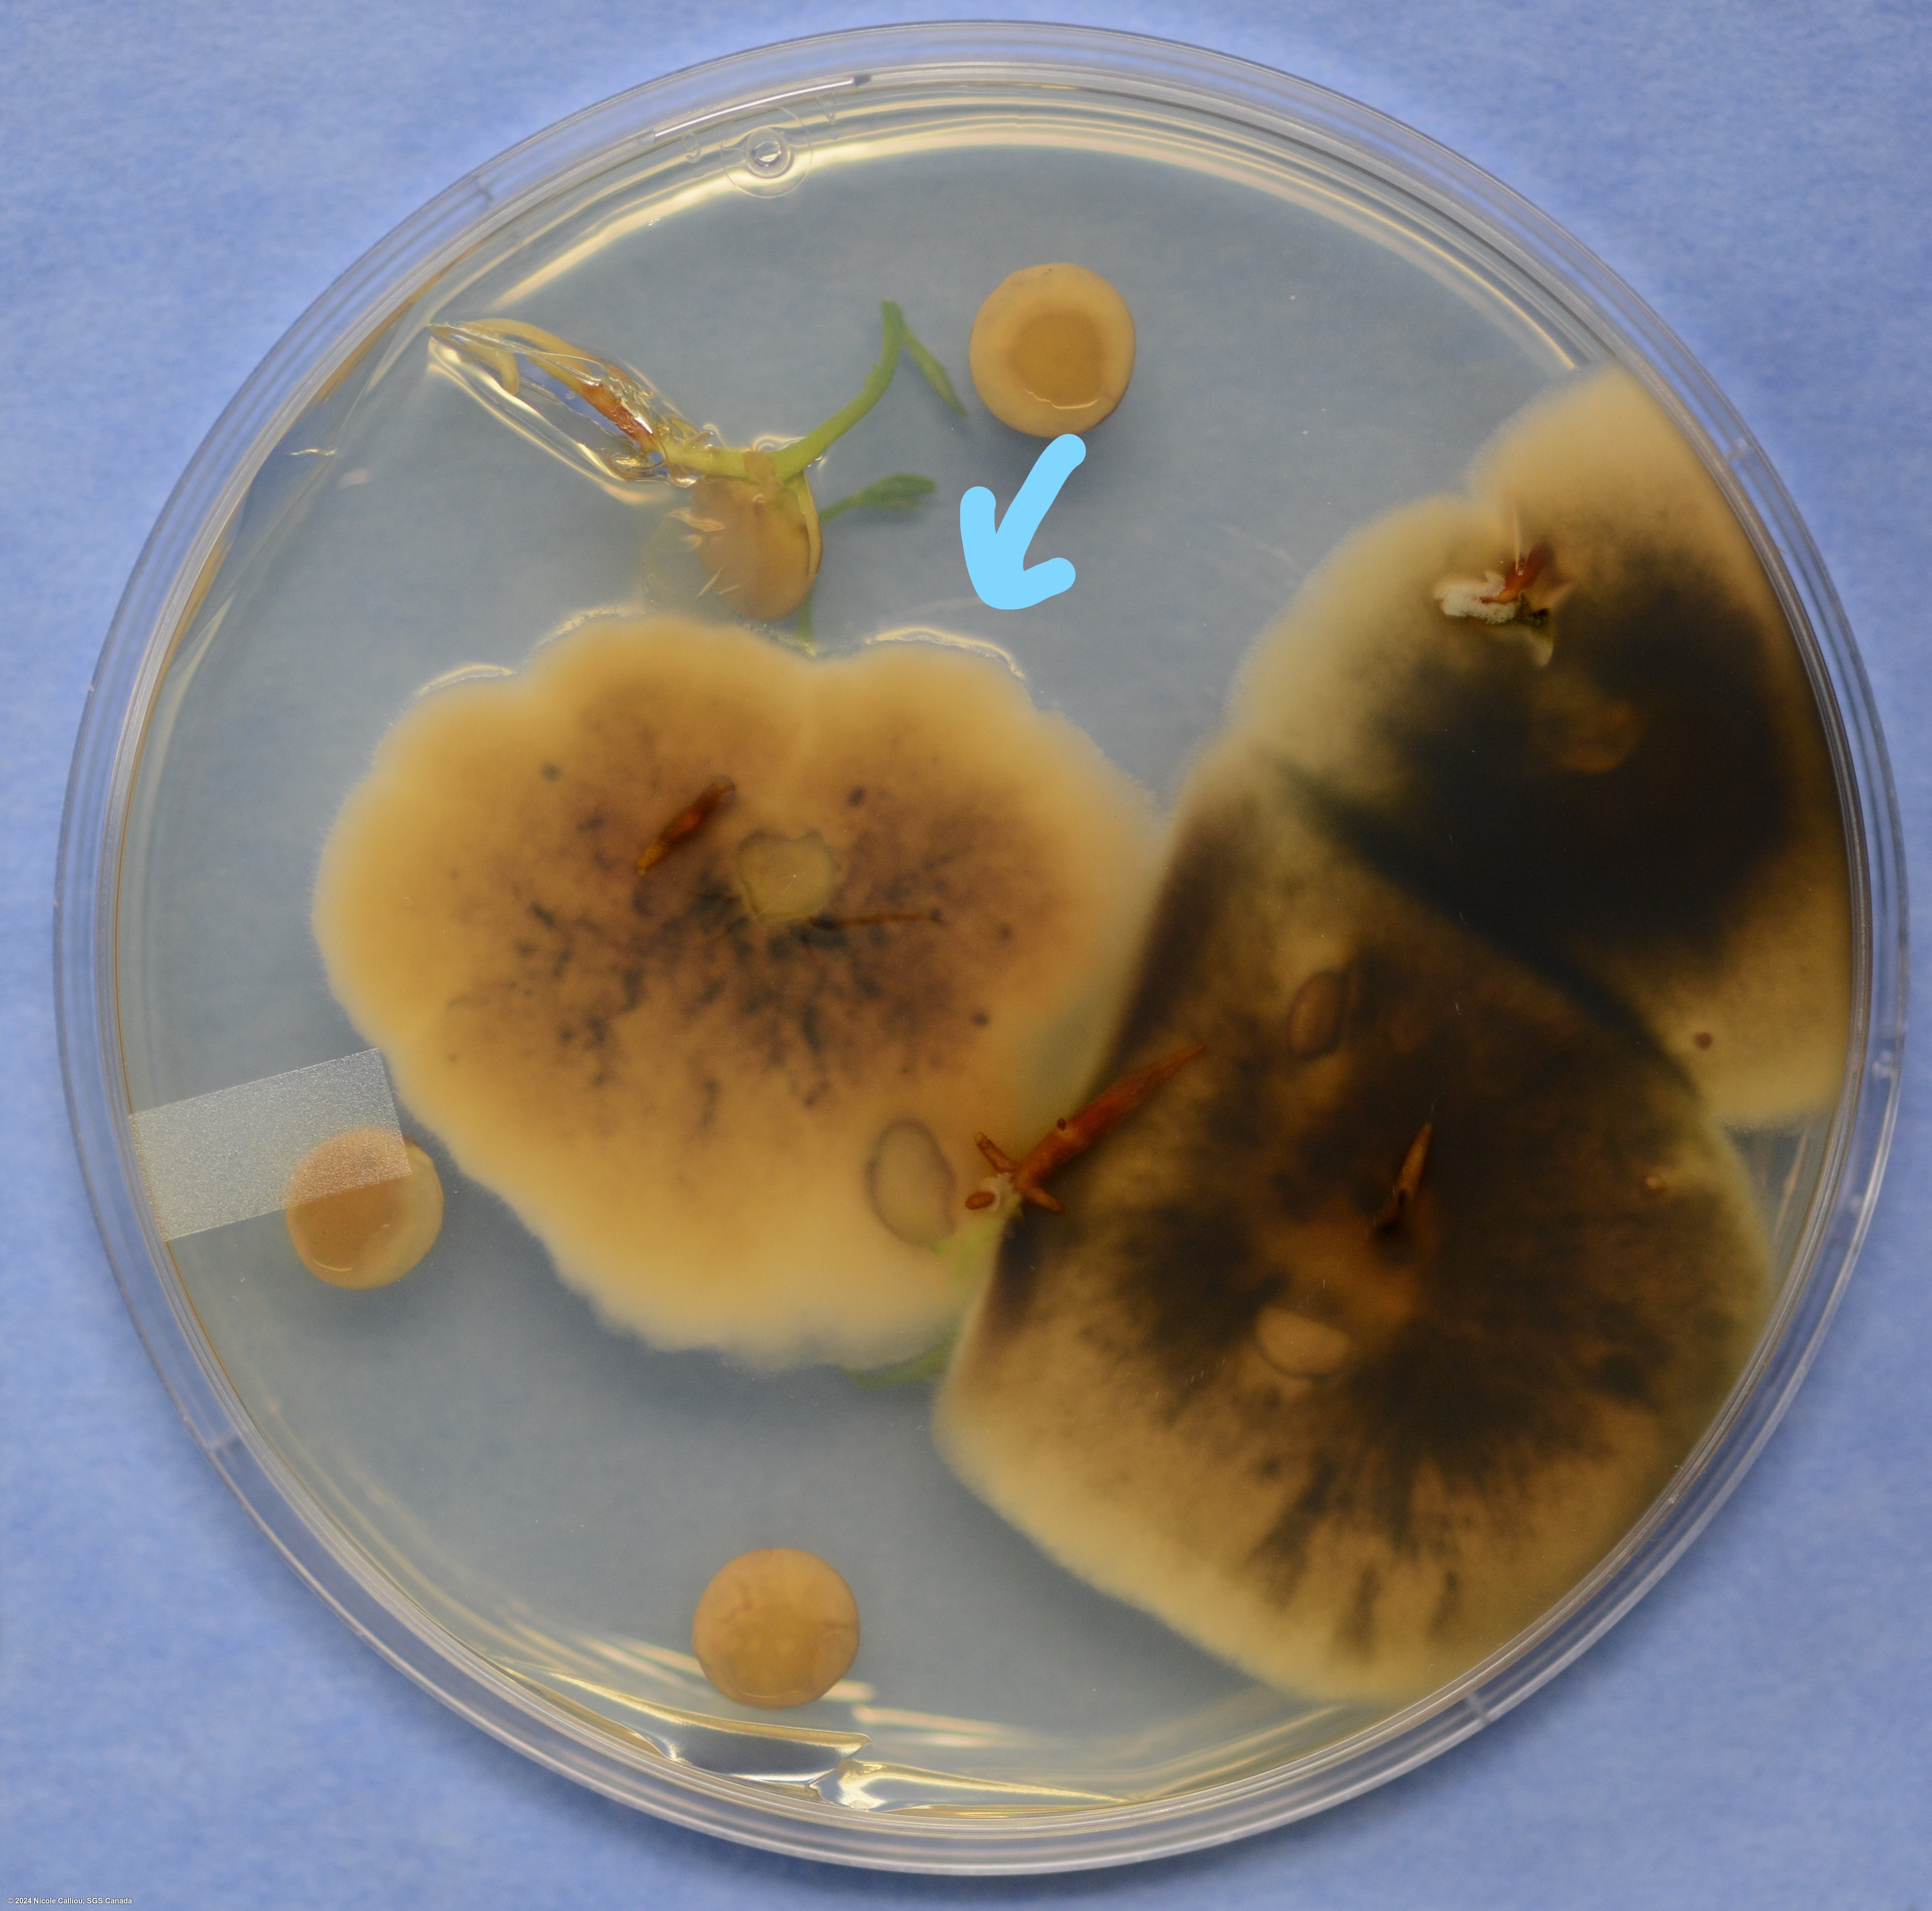

Pathogen
Stemphylium spp.
Overview
|
Scientific name
|
Stemphylium spp. |
|
Genus
|
Stemphylium |
|
EPPO code
|
STEMSP |
|
Common name
|
Stemphylium leaf spot |
|
Synonyms
|
|
Description
Commonly identified by the distinctive spores. Described in the ISTA 'Common Laboratory Seed Health Testing Methods for Detecting Fungi' as conidia being smooth walled, a few minutely echunulate, and/or verrucose, and appearing as rpundish square to rectangular packets of different sizes, with both transverse and longitudinal septa, pale to dark brown.